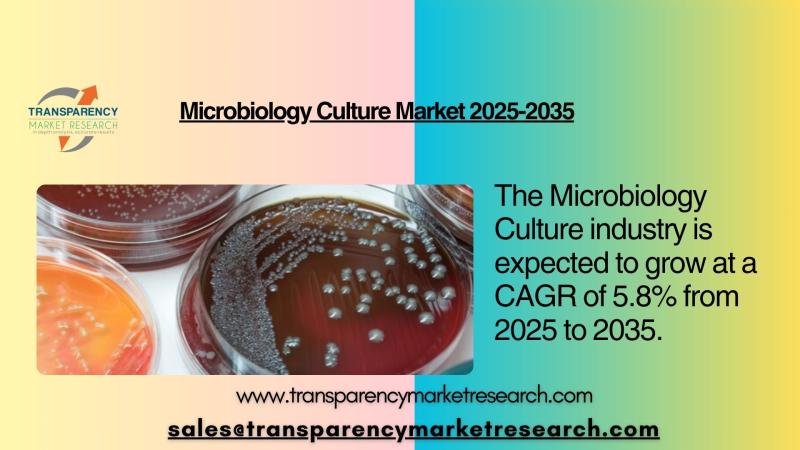

Press release
Next-Generation Sequencing for Non-Invasive Prenatal Testing Market to Witness Steady Expansion During 2016 - 2024
Non-invasive prenatal testing is gradually being accepted by pregnant women with high-risk for screening common fetal chromosomal aneuploidies such as Edward’s syndrome (trisomy 18), Down syndrome (trisomy 21), Turner syndrome (monosomy X) and Patau syndrome (trisomy 13). Accuracy, safety, and non-invasiveness are the key factors credited to the acceptance of these tests amongst gynecologists and expecting mothers related to invasive tests such as amniocentesis and chorionic villus sampling (CVS). MaterniT21 was the first NIPT introduced in October 2011 by Sequenom, Inc. of the U.S. Since then, it has been the leader of the market, accounting for the biggest share in terms of volume as well as revenue. However, BGI’s NIFTY is likely to overtake MaterniT21 PLUS in terms of volume in the global market. Sequenom, Inc. is likely to maintain its leadership position in North America through 2024. Panorama, verifi, informaSeq, Harmony, VisibiliT, BambniTest and PrenaTest are the other commercially available NIPTs for detecting chromosomal abnormalities.Next generation sequencing is used in the sequencing technologies that immensely parallelize the DNA sequencing process rather than limited few fragments or to a single of DNA. The next generation sequencing (NGS) technology permits rapid sequencing and yields thousands and millions of sequences in single run using next generation sequencers. Such technologies have been rapidly developing owing to the constant demand for high-throughput sequencers which incline to lesser the cost of DNA sequencing.
A sample of this report is available upon request @ https://www.transparencymarketresearch.com/sample/sample.php?flag=B&rep_id=14135
According to the Department of Biology, University of Copenhagen, There are almost 7000 rare diseases that have been reported globally. Although most of them occur with an incidence of less than one in 2000, in total around 6% of the population suffers from rare diseases. These rare diseases are mostly caused by changes in genes, which is presently lack of effective treatment. The quick advancement of next generation sequencing technology boosts the discovery of new causative gene for these rare diseases, as well as the genetic diagnosis in clinic practice. The innovation of cell-free fetal DNA, coupling with next generation sequencing, makes NIPT possible for rare diseases. However, for most of the current routine prenatal genetic testing for rare diseases require collection of fetal samples through an invasive process, which sometimes might lead to maternal anxiety, or even lead to miscarriage. Hence, developing an effective method to perform noninvasive prenatal test (NIPT) for rare diseases is the crucial challenge to inhibit birth defect in the future.
The exponential progress of the NIPT market is supported by factors such as no risk of miscarriage with NIPT, high incidence rate of babies born with Down syndrome, and shifting trend toward child bearing at advanced maternal age. Maternal age is closely related to the risk of developing a fetus with chromosomal abnormalities; hence, rising maternal age is likely to contribute to the increasing incidence of babies born with chromosomal aneuploidies.
Geographically, the market for non-invasive prenatal testing products has been segmented into North America, Europe, Asia Pacific, Latin America, and Middle East & Africa. Europe is the biggest market with more number of cases followed by North America. Adoption in Asia pacific is lesser due to less awareness. North America is expected to grow at highest CAGR in the forecast period. According to Down Syndrome Education (DSE), the incidence rate for Down syndrome is one in every 830 children births in the U.S., while the incidence rate is one in every 920 babies born in Europe, indicating a large potential consumer base for NIPT. Conventional invasive prenatal genetic tests such as chorionic villus sampling (CVS) and amniocentesis are related with the risk of miscarriage; hence, these are being replaced with new non-invasive prenatal tests. These new NIPTs are based on the analysis of cell-free DNA floating in the maternal plasma and pose no risk of miscarriage.
To view TOC of this report is available upon request @ https://www.transparencymarketresearch.com/sample/sample.php?flag=T&rep_id=14135
Some of the market players in this industry are., Illumina, Inc., Agilent Technologies, Inc, Biomatters, Ltd., BGI (Beijing Genomics Institute), Pacific Biosciences, Oxford Nanorpore Technologies, Ltd., Dnastar, Inc., Life Technologies Corporation, EMC Corporation, Genomatix Software GMBH, Ocimum Biosolutions, Ltd., Macrogen, Inc., Partek Incorporated, Qiagen N.V., Perkinelmer, Inc., Knome, Inc. and GATC biotech AG.
The report offers a comprehensive evaluation of the market. It does so via in-depth insights, understanding market evolution by tracking historical developments, and analyzing the present scenario and future projections based on optimistic and likely scenarios. Each research report serves as a repository of analysis and information for every facet of the market, including but not limited to: Regional markets, technology developments, types, applications, and the competitive landscape.
About US
Transparency Market Research (TMR) is a next-generation provider of syndicated research, customized research, and consulting services. TMR’s global and regional market intelligence coverage includes industries such as pharmaceutical, chemicals and materials, technology and media, food and beverages, and consumer goods, among others. Each TMR research report provides clients with a 360-degree view of the market with statistical forecasts, competitive landscape, detailed segmentation, key trends, and strategic recommendations.
Contact US
Abhishek Budholiya
State Tower,
90 State Street,
Suite 700,
Albany NY - 12207
United States
Tel: +1-518-618-1030
Website: https://www.transparencymarketresearch.com/
Email: sales@transparencymarketresearch.com
This release was published on openPR.
Permanent link to this press release:
Copy
Please set a link in the press area of your homepage to this press release on openPR. openPR disclaims liability for any content contained in this release.
You can edit or delete your press release Next-Generation Sequencing for Non-Invasive Prenatal Testing Market to Witness Steady Expansion During 2016 - 2024 here
News-ID: 825415 • Views: …
More Releases from Transparency Market Research

Biologics Market Outlook 2035: Global Market to Reach USD 1,140.2 Billion by 203 …
The global biologics market is entering a dynamic growth phase, shaped by significant advancements in biotechnology, increasing prevalence of chronic diseases, and a rising demand for targeted therapies. Biologics-complex molecules derived from living organisms-are transforming the landscape of modern medicine, enabling more effective and personalized treatments for conditions such as cancer, autoimmune disorders, diabetes, and infectious diseases. In 2024, the global biologics industry was valued at US$ 448.8 billion, and…
Microbiology Culture Market Outlook 2035: Global Industry Valued at USD 16.4 Bn …
The global microbiology culture market is undergoing a significant transformation, driven by advancements in biotechnology, growing healthcare needs, and expanding applications in pharmaceuticals, food safety, and environmental testing. In 2024, the market was valued at US$ 8.8 billion, highlighting its crucial role in research, diagnostics, and industrial microbiology. Over the next decade, the industry is projected to experience robust expansion, fueled by heightened investments in clinical diagnostics, the emergence of…

Remote Patient Monitoring Devices Market Outlook 2035: Global Market Valued at U …
The global remote patient monitoring (RPM) devices market is witnessing an unprecedented transformation driven by advancements in digital healthcare, the proliferation of connected medical technologies, and the growing emphasis on patient-centric care models. In 2024, the market was valued at US$ 11.8 billion, signaling strong momentum in adoption across hospitals, clinics, and homecare environments. As healthcare systems increasingly prioritize preventive care, telemedicine, and chronic disease management, remote patient monitoring has…

Wound Healing Market Outlook 2035: Industry Valued at US$ 45.5 Bn by 2035, Advan …
The global wound healing market is entering a transformative phase, driven by advancements in biotechnology, regenerative medicine, and personalized care solutions. The industry, valued at US$ 28.9 billion in 2024, plays a critical role in healthcare by addressing acute, chronic, and surgical wounds that affect millions of patients worldwide. Increasing prevalence of diabetes, obesity, and cardiovascular diseases, along with a rising aging population, is significantly contributing to the demand for…
More Releases for NIPT
Noninvasive Prenatal Testing (NIPT) Market | Counsyl, Illuminansyl, Intergrated …
The global noninvasive prenatal testing (nipt) market report is a comprehensive report that provides a detailed analysis of the current status and future trends of the noninvasive prenatal testing (nipt) market worldwide. This report provides valuable information to industry stakeholders by offering an in-depth perspective on market dynamics, competitive landscape, growth opportunities, and key challenges faced by industry participants.
From the perspective of market dynamics, this report explores the factors driving…
Noninvasive Prenatal Testing (NIPT) Market global outlook and forecast 2021 -202 …
The Global Noninvasive Prenatal Testing (NIPT) Market research report is a careful examination of the worldwide industry which has been a region of enthusiasm for a Noninvasive Prenatal Testing (NIPT) makers, organizations, authorities, chiefs, and likely speculators, and analysts. The report profoundly lights up noteworthy features in the business, including a contention situation, condition, portions, showcase size, share, gainfulness, development potential, and advancements.
The…
Non Invasive Prenatal Testing (NIPT) Market Worth $13.1 Billion by 2027
Meticulous Research- leading global market research company published a research report titled "Non Invasive Prenatal Testing (NIPT) Market by Product & Solution (Consumables, Systems, Software), Method (Ultrasound Screening, Cell Free DNA Test), Application (Trisomy, Microdeletions, Monosomy), and End-user (Diagnostic Labs) - Global Forecast to 2027". According to this latest publication from Meticulous Research, the global non-invasive prenatal testing market is expected to grow at a CAGR of 17.1% from 2019…
Non-Invasive Prenatal Testing Market has been analyzed from 2 viewpoints: NIPT T …
Worldwide Market Reports recently released “Global Non-Invasive Prenatal Testing Market Research Report 2017” that centers around the latest developing trends and technologies in the Non-Invasive Prenatal Testing Market having Five Years of forecast period from 2017 to 2022 and considering Market status study from 2017 to 2022.
During the research, noteworthy data was collected in order to shape the research document and make it a valuable resource for managers, industry executives…
Indian NIPT Market Outlook 2022
ReportsWorldwide has announced the addition of a new report title Indian NIPT Market Outlook 2022 to its growing collection of premium market research reports.
NIPT helps obstetricians and pregnant women over different age-groups to better manage their pregnancy at a very early stage. Over the last few years, an increasing number of women in Tier-1 cities in India are giving preference to their career, and are opting for childbearing at a…
Non-Invasive Prenatal Testing (NIPT) Market Forecast 2017-2021
Non-invasive prenatal testing (NIPT) has received importance in the recent past due to increasing awareness about genetic disorders and availability of accurate noninvasive tests. NIPT testing is non-invasive has no risk of miscarriage as compared to other tests such as chorionic villus sampling (CVS) or amniocentesis. Down syndrome is one of most commonly diagnosed using NIPT. Some of the key genetic disorders diagnosed using NIPT include Edward's syndrome, Patau syndrome…
